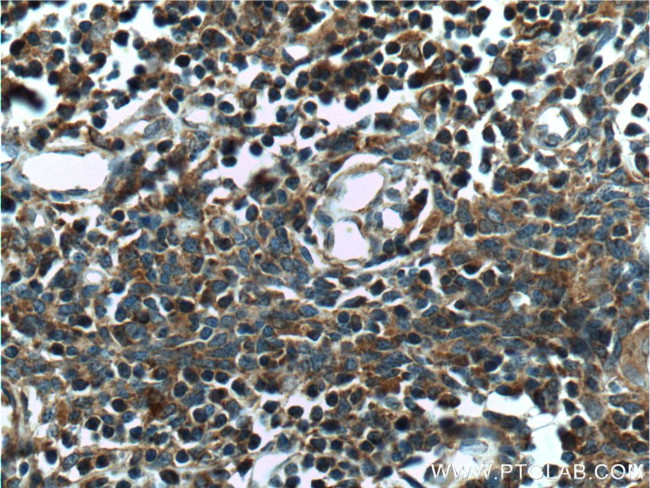
COMMD3 Antibody in Immunohistochemistry (Paraffin) (IHC (P))

Search
Proteintech
COMMD3 Polyclonal Antibody
{{$productOrderCtrl.translations['antibody.pdp.commerceCard.promotion.promotions']}}
{{$productOrderCtrl.translations['antibody.pdp.commerceCard.promotion.viewpromo']}}
{{$productOrderCtrl.translations['antibody.pdp.commerceCard.promotion.promocode']}}: {{promo.promoCode}} {{promo.promoTitle}} {{promo.promoDescription}}. {{$productOrderCtrl.translations['antibody.pdp.commerceCard.promotion.learnmore']}}
产品信息
26240-1-AP
种属反应
宿主/亚型
分类
类型
抗原
偶联物
形式
浓度
规格
纯化类型
保存液
内含物
保存条件
运输条件
产品详细信息
Immunogen sequence: RSFDSNAFT LLLRAAFQSL LDAQADEAVL DHPDLKHIDP VVLKHCHAAA ATYILEAGKH RADKSTLSTY LEDCKFDRER IELFCTEYQN NKNSLEILLG SIGRSLPHIT DVSWRLEYQI KTNQLHRMYR PAYLVTLSVQ NTDSPSYPEI SFSCSMEQLQ DLVGKLKDAS KSLERATQL (18-195 aa encoded by BC022898)
靶标信息
COMMD3 may modulate activity of cullin-RING E3 ubiquitin ligase (CRL) complexes. may down-regulate activation of NF-kappa-B. Modulates Na(+) transport in epithelial cells by regulation of apical cell surface expression of amiloride-sensitive sodium channel (ENaC) subunits.
仅用于科研。不用于诊断过程。未经明确授权不得转售。
生物信息学
蛋白别名: Bmi-1 upstream gene protein; Bmi1 upstream; Bup protein; COMM (copper metabolism MURR1) domain containing 3; COMM domain-containing protein 3; Protein Bup; Protein PIL; unnamed protein product
基因别名: AW550818; BUP; C10orf8; COMMD3; D2Ertd542e
UniProt ID: (Human) Q9UBI1, (Mouse) Q63829
Entrez Gene ID: (Human) 23412, (Mouse) 12238